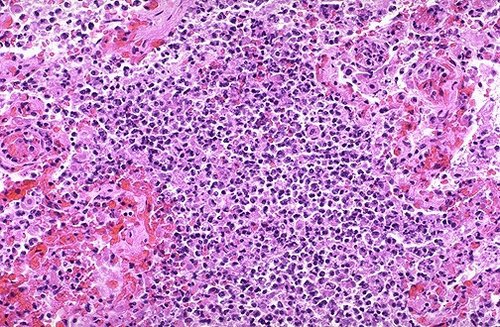
看图识病肺部疾病的生理病理图片

病理学图谱

胃镜,肠镜镜下所见与病理切片诊断 - 消化内科讨论版 - 爱爱医医学
图片尺寸2020x733
病理学中心实验室
图片尺寸640x557
病理切片
图片尺寸1080x1439
阳泉市第三人民医院成功举办阳泉市卫健委病理质控会暨临床病理讨论会
图片尺寸1028x718
看图识病肺部疾病的生理病理图片
图片尺寸500x327
一个测试|5张病理图片你能看出啥?
图片尺寸800x438
食道和胃病理学图谱
图片尺寸730x852
病理学切片4
图片尺寸706x502
病理学教学彩色图谱(附光盘) (附光盘)
图片尺寸1280x1782
食道和胃病理学图谱
图片尺寸690x1019
病理学切片四
图片尺寸960x720
吉非替尼治疗哪种程度的肺癌_肺癌的分类及恶性程度_巴仙吉犬掉毛程度
图片尺寸1000x514
病理学实验图
图片尺寸2560x1920
68奈特病理学彩色图谱知识点整理
图片尺寸1080x1440
腺泡腺癌组织学变型的改变:2016版who分类腺泡腺癌组织学变型中萎缩型
图片尺寸1949x1623
病理学切片图片库
图片尺寸1080x810
病理学(医学高级):十二章泌尿系统疾病题库考点(考试必看)
图片尺寸397x586
食道和胃病理学图谱
图片尺寸693x1019
恶性肿瘤:嫌色细胞型肾细胞癌解剖病理图谱 _泌尿系统 | 天山医学院
图片尺寸661x496
食品工业科技 2021 42(16): 325-330 he染色小鼠结肠组织病理
图片尺寸1575x1988